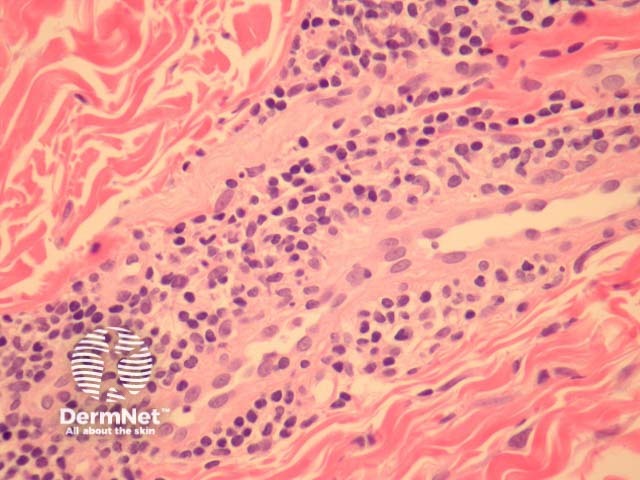
Figure 2
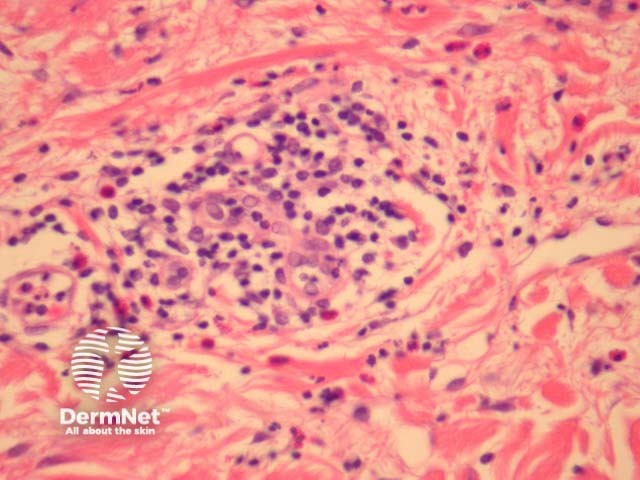
Figure 4

Main menu
Common skin conditions
NEWS
Join DermNet PRO
Read more
Quick links
Author: Harriet Cheng BHB, MBChB, Dermatology Unit, Waikato Hospital; A/Prof Patrick Emanuel, Dermatopathologist, Auckland, New Zealand, 2013.
Perniosis or chilblains are a localised form of vasculitis presenting with reddish purple bumps in reaction to cold exposure. Blistering and ulceration may occur.
In perniosis, sections show acral skin with a dense superficial and deep lymphocytic infiltrate (figure 1). Subepidermal oedema may be marked. The characteristic feature is lymphocytic perivascular infiltrate within the dermis and sometimes extending to the subcutis (figures 2, 3). This is thought by some authors to represent the one true “lymphocytic vasculitis”, as there may be well established fibrinoid change and thrombosis can occur. There may be numerous eosinophils in early lesions (figure 4).

Figure 1
Figure 2

Figure 3
Figure 4

Figure 5
Chilblain lupus erythematosus: Frank lymphocytic vasculitis and interface changes are more common in chilblain lupus than in idiopathic chilblains (figure 5). A positive antinuclear antibody test favours chilblain lupus erythematosus.